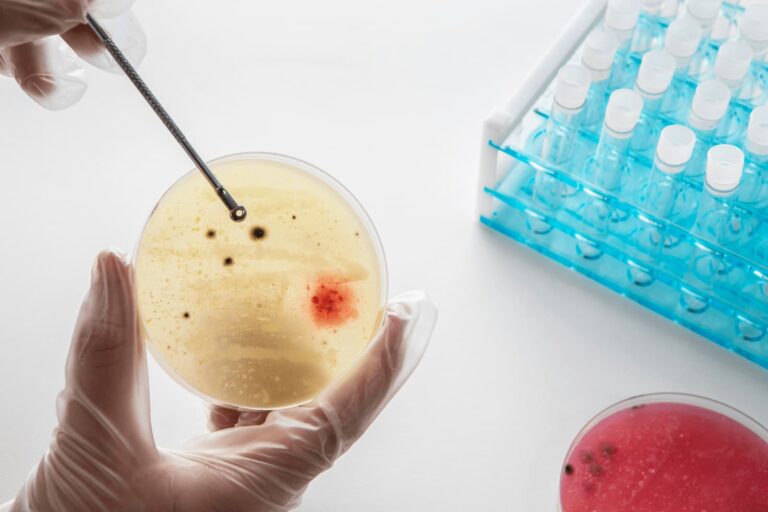

Клініка у місті Бориспіль
Медичні довідки
Консультації лікарів
















Аналізи

Інші послуги












Медичний огляд у Борисполі: медогляди та довідки
Медичний огляд у Борисполі – це сучасний медичний центр, який надає можливість пройти медичні обстеження та отримати довідки для працевлаштування, навчання, керування транспортними засобами й особистих потреб. Фахівці забезпечують оперативне обслуговування, точну діагностику та оформлення офіційних документів з урахуванням вимог чинного законодавства України.
Медичний центр у Борисполі: послуги з проходження медичних оглядів
Перевірений медичний центр у Борисполі надає повний спектр послуг для фізичних осіб, комерційних структур і державних установ. До основних видів медичних оглядів, які проводить заклад, належать:
- попередні та періодичні огляди;
- професійні медичні огляди для працівників;
- оформлення медичних довідок;
- виїзні медичні комісії.
Медичний центр «Medoglad+» забезпечує якісне, швидке та офіційно підтверджене проходження медичних оглядів із дотриманням усіх нормативних вимог.
Медичні довідки в Борисполі: оформлення та ціни
Медичні довідки в Борисполі у центрі «Медогляд» – це швидке оформлення офіційних документів за доступними цінами. Центр оформлює такі види довідок:
- для навчання та працевлаштування;
- для водіїв;
- для відвідування басейну;
- для дітей і дорослих.
Вартість послуг формується за принципом прозорості: ціни залежать від виду довідки.
Медичний огляд у Борисполі: процедури, вимоги та умови
Медичний огляд у Борисполі проводять кваліфіковані лікарі медичного центру. Проходження цієї процедури необхідне для роботи, навчання та інших цілей. До основних процедур, які виконують фахівці, належать:
- огляд лікарями;
- проведення лабораторних аналізів;
- функціональна діагностика;
- консультації профільних лікарів.
У центрі здійснюється попередній запис на послуги за умови пред’явлення документа, що посвідчує особу.






Графік роботи:
Пн-Пт: 08:00 – 18:00
Сб: 09:00 – 14:00
Нд: вихідний


Графік роботи:
Пн-Пт: 08:00 – 16:00
Сб: 09:00 – 13:00
Нд: вихідний


Графік роботи:
Пн-Пт: 09:00 – 17:00
Сб: 09:00 – 13:00
Нд: вихідний


Графік роботи:
Пн-Пт: 09:00 – 16:00
Сб: 09:00 – 13:00
Нд: вихідний


Графік роботи:
Пн-Пт: 08:00 – 16:00
Сб: 09:00 – 13:00
Нд: вихідний










